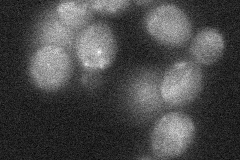
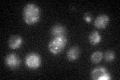

View description
Probable catalytic subunit of a mannosylinositol phosphorylceramide (MIPC) synthase, forms a complex with probable regulatory subunit Csg2p; function in sphingolipid biosynthesis is overlapping with that of Csh1p
Localization:
Intensity:
Fold change:
Significance:
-
C’ GFP library in SD

vacuole26.47 -
N' NOP1pr-GFP in SD

vacuole,bud neck33.8037 -
N' TEF2pr-mCherry in SD

vacuole30.9455 -
N' NATIVEpr-GFP in SD

below threshold21.8868 -
N' TEF2pr-VC and Cyto-VN in SD
below threshold23.1564 -
C’ GFP library in SD+DTT

vacuole57.332.16Yes -
C’ GFP library in SD+H2O2

vacuole22.010.83No -
C’ GFP library in Starvation Media
vacuole47.211.78Yes -
C’ GFP library on the background of Pup2-DaMP

vacuole -
C’ GFP library on the background of CCT mutant

vacuole26.7651.01059No
